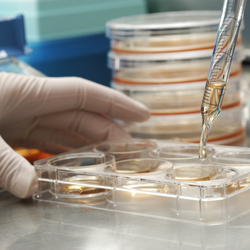

|
|
Harlem Children's Zone (1971)
|

|
|
Sheltering Arms (1888)
|

|
|
Doctors Without Borders (1990)
|

|
|
Alvin Ailey Foundation (1968)
|

|
|
Action Against Hunger (1979)
|

|
|
Starkey Hearing Foundation (1973)
|
|
|
Cancer Research Institute (1953)
|

|
|
National Urban League (1910)
|

|
|
Step Up For Students (2000)
|

|
|
The Sierra Club Foundation (1960)
|

|
|
Breast Cancer Research (1993)
|

|
|
Helen Keller International (1915)
|

|
|
American Kidney Fund (1971)
|

|
|
Henry Street Settlement (1893)
|

|
|
Actors Fund of America (1882) |

|
|
Charity Water (2006) |

|
|
American Heart Association (1949) |

|
|
Environmental Defense Fund (1967)
|

|
|
PetSmart Charities (1994)
|

|
|
National Council of La Raza (1968)
|

|
|
The Humane Society (1954)
|

|
|
Africare (1970)
|

|
|
Oxfam America (1942)
|

|
|
Metropolitan Family Services (1857)
|
|
|
Ronnie Moas in the Media
|
|
| (January through August 2014) |
|
|
The Disciplined Investor / August 21
Interview with Andrew Horowitz
|
Interview / Cover Story / August 15
South Florida Business Journal
|
Taking Stock with Pimm Fox
Bloomberg television / August 12
|
Keiser Report with Max Keiser
Russia Today / E619 / June 26
|
Howard University Radio / June 4
Interview with Carl Joseph WHUR
|
Keiser Report with Max Keiser
Russia Today / E608 / May 31
|
Interview with Ric Young
Voice of Russia / May 23
|
Breaking the Set with Abby Martin
Russia Today / May 22
|
Interview with Joel Elconin
Benzinga / May 14
|
Interview with Tim Danahey
Tim Danahey Show / April 11
|
Interview with Julien Cadot
RageMag France / March 21
|
The Willis Report with Gerri Willis
Fox Business / January 18
|
Taking Stock with Pimm Fox
Bloomberg television / January 17
|
MoneyBeat with Paul Vigna
Wall Street Journal / January 16
|
Fast Money with Melissa Lee
CNBC / January 15
|
Interview with Ric Young
Voice of Russia / January 9
|
Interview with Al Lewis
MarketWatch / January 8
|
|
If you want to follow Ronnie Moas
and his two interests -- Standpoint
Research and Philanthropy & Philosophy
– please send a friend request here
https://www.facebook.com/
ronnie.moas
and then go here and click "Like"
https://www.facebook.com/
pages/Standpoint-Research/336149794492?ref=hl
|
|
|
Below (in blue font) are excerpts from a speech Robert Kennedy gave on March 18, 1968. We have made very little progress and I am absolutely committed and hell-bent on changing this. Everyone is to blame -- especially the conservatives and the wealthy.
|
|
Excerpts from Robert Kennedy speech -- March 18, 1968 – we have made very little progress
|
|
Many in this country we see are suffering. Then there are millions more living in hidden places, whose names and faces are completely unknown -- but I have seen these other Americans. I have seen children in Mississippi starving, their bodies so crippled from hunger and their minds have been so destroyed for their whole life that they will have no future. I have seen children in Mississippi -- here in the United States -- in the Delta area with distended stomachs, whose faces are covered with sores from starvation, and we haven't developed a policy so we can get enough food so that they can live, so that their children, and their lives are not destroyed. I don't think that is acceptable in the United States of America and I think we need a change.
|
|
I have seen Indians living on their bare and meager reservations, with no jobs, with an unemployment rate of 80%, and with so little hope for the future, that for young people in their teens, the greatest cause of death among them is suicide.
|
|
That they end their lives by killing themselves -- I don't think we have to accept that -- for the first American, for this minority here in the United States. If young boys and girls are so filled with despair when they are going to high school and feel that their lives are so hopeless -- that nobody is going to care for them, nobody is going to be involved with them, and nobody is going to bother with them, that they either hang themselves, shoot themselves or kill themselves -- I don't think that is acceptable and I think the United States of America can do much better.
|
|
I have seen the people of the black ghetto, listening to ever greater promises of equality and of justice, as they sit in the same decaying schools and huddled in the same filthy rooms -- without heat -- warding off the cold and warding off the rats.
|
|
If we believe that we, as Americans, are bound together by a common concern for each other, then an urgent national priority is upon us. We must begin to end the disgrace of this other America.
|
|
And this is one of the great tasks of leadership for us, as individuals and citizens this year. Even if we act to erase material poverty, there is another greater task, it is to confront the poverty of satisfaction that afflicts us all. Too much and for too long, we seemed to have surrendered personal excellence and community values in the mere accumulation of material things.
|
|
|
PHILANTHROPY, JUSTICE, ACTIVISM & EDUCATION
|
|
I built this website in 2014. It has Not been updated since 2015. I will probably be updating it in late 2018 (or early 2019). I was extremely busy the last two years and I focused my philanthropic efforts exclusively on one large charity during that time (while neglecting this website of mine). I raised more than $430,000 for that charity during the last two years (through March 2018). I have recently decided to go back to my original plan -- instead of focusing all my attention on one charity, going forward, I will divide up my attention among the 24 charities highlighted on this website. Although the site has not been updated in three years, it is Not outdated. You can click on each of the 24 images that you see scrolling down the left side of the Home page, and open up a report for that respective charity. Please find a few causes that you like and SEND THEM YOUR DONATIONS DIRECTLY. When this website was built in 2014, I did place a donate button on this website for whoever wanted to help me cover the expenses; the time it took to build the site; update and maintain the site; and drive traffic to the site. I am NO longer requesting donations. My personal financial situation has improved significantly since then, therefore, I do not need any assistance with this project. Please just donate directly to whichever charities strike a nerve with you and share the link to this site whenever you can with whoever you can. All 24 charities were pre-screened on several criteria and received high grades from the charity monitor websites and watchdogs. I will try to update this website in the next 6-12 months. The main item that will change is that the financial statements for each charity highlighted in this report are ~four years old and I need to update those statements. I assume that the charity ratings agencies have not changed the ratings on all or most of these names.
|

|
|
CLICK HERE FOR 44-PAGE REPORT FROM FEBRUARY 24, 2014 BLACKLISTING PHILIP MORRIS, YAHOO, AMAZON & APPLE ON ETHICAL AND MORAL GROUNDS TITLED -- EXTREME CAPITALISM AND THE RACE TO THE BOTTOM
|
|
What is www.philanthropyandphilosophy.com?
|
|
Philanthropy & Philosophy was created in order to educate; seek justice; tell the truth; raise awareness and activism; and encourage more charitable giving and philanthropy. I am nauseated and infuriated by what I see in our society and will try to change the system until I am out of breath. Speaking nicely to the upper classes and corporations has gotten the poor and unfortunate in this world -- and those speaking on their behalf -- nowhere. I am going to take a more aggressive approach and hopefully the results will be better. If I am forced to humiliate those at the top -- I will.
|

|
Ronnie Moas, Founder of Philanthropy and Philosophy
on CNBC calling for wealth redistribution and fair wages to be paid
to employees before shareholders are paid. Please go to the Videos
page to see additional video clips and interviews with Ronnie and follow
his fight against vulture capitalism and the gap between rich and poor worldwide.
|
|
The goals of this site and organization are to help eliminate/cripple the tobacco industry; reduce the gap between rich and poor worldwide via higher minimum wages and lower maximum wages; higher taxes, closing tax loopholes, and wealth redistribution; push for limits on executive compensation; and improvement in the way service providers, farmers, assembly line workers, janitors, clerks, security people, taxi drivers, sweatshop workers and other low-wage workers worldwide are treated. They have historically been abused, under-appreciated and under-paid for centuries and this needs to stop. Maybe one day all low workers will go on strike for a couple of weeks and that will paralyze this country (and other countries) for a short time. Only then will people realize how important these people are to us and realize how disgraceful it is the way we under-value and under-appreciate what they do for society.
|
|
Enough is Enough
|
|
On the stock exchange Apple is now valued at $510 BILLION dollars and they sit on $140 BILLION in cash (Q1, 2014). Their assembly line workers in Asia make $3 an hour - and many have already committed suicide. Philip Morris is now valued at $135 BILLION dollars and they continue to operate legally in an industry that is responsible for 5,000,000 deaths annually -- including 500,000 innocent second-hand smoking victims. In China alone, 180,000,000 children are exposed to second-hand smoke. Amazon is now valued at $185 BILLION as their Founder and CEO Jeff Bezos sits on $27 BILLION - his warehouse employees have nothing and barely survive on their ~ $10 an hour wage. This is a disgusting system we have. Extreme capitalism spiraling out of control where shareholders in just these three companies now have $830 BILLION while the Apple assembly line workers in Asia and Amazon warehouse employees have NOTHING. As for the death and destruction coming from Philip Morris - 50% of their tobacco customers are either dead or dying.
|
|
Income Inequality and Corporate Abuse of Power
|
|
It was reported recently that CVS has one of the highest gaps between CEO salary and median employee salary. CEO Larry Merlo -- 2013 pay was $12.1 million. Median employee pay at CVS -- $28,700. The ratio of CEO-to-worker pay is more than 400-to-1. This a disgusting example of the extreme capitalism that is so infuriating and nauseating to me and tens of millions of people in this country. Enough is enough. The shareholders are now sitting on $90 BILLION with Directors and Executives Brown, Piccolo, Benton and Merlo with more than $50,000,000 worth of stock and taking home a combined $25,000,000 in pay for the year. According to my math the score right now is: CVS shareholders: $90 BILLION -- against money in the savings accounts of the hundreds of thousands of workers who worked on the bottom half of the CVS ladder in the last few decades: Near Zero.
|
|
Consumers need to boycott rackets like this -- or at the very least cut back on what they spend. Employees need to strike until they are treated like human beings and not animals. There is no place in society for this anymore. CVS earned Net Income after taxes of $4.78 billion last year. They could have paid out a $10,000 bonus to every one of their 70,000 employees who are below $12 an hour and still turned a $4 billion profit. Unfortunately, the greedy multi-millionaire and billionaire shareholders have a problem with this. They want to continue to stuff their bank accounts while others - the very employees who made the $4.78 billion possible -- struggle to survive.
|
|
CVS gives everything to the insiders and shareholders and nearly nothing to the employees -- they letCVS employees work 40 hours a week for $500 that allows them to afford life in a poor, rat, drug, prostitute and roach infested neighborhood. How can anyone with a heart and conscience accept this?
|
|
To add insult to injury -- CVS is now replacing the cashiers who barely make more than minimum wage with check-out kiosk machines, so that they can turn a higher profit this year and pay the shareholders and insiders more than what they made last year. Kick the cashiers to the street and put more money into the multi-millionaire and billionaire shareholders' pockets. There are hundreds of examples like this kind of corporate behavior present in our society and it is a cancer that must be eliminated. This disgusting system needs to end once and for all – and it is going to!
|
|
Capitalism is a Rigged system
|
|
The current system disproportionately benefits a few at the top -- at the expense of the middle and lower classes. The top one percent in this world is now worth $110 TRILLION. The bottom 50% -- 3.5 BILLION people -- has less than $1.7 trillion dollars and lives on less than $4 a day. The top 1% has 65 times what the bottom 50% has. The 100 wealthiest individuals in the world now control more wealth than half of the world population. Anyone who argues against my demand for wealth redistribution is either immoral / unethical / selfish / greedy and/or disconnected financially / emotionally / physically from reality and the poor/unfortunate in this world. I have heard ALL of the arguments against wealth redistribution and none of them make any sense. Mainly, the arguments are coming from the wealthy, and right-wing (conservatives) who are happy with everything as is and do not really give a damn about anyone or anything outside the bubble they live in. Everyone is to share the blame for the condition this world is in with five billion people at, near or below the poverty line. That being said, I pin most of the blame on one group in particular and that is the wealthy conservatives. Their trickle down economic theories are bullsh*t. Nothing ever trickles down to the poor. Starbucks is now valued at more than $50 BILLION – the coffee-bean pickers in Central America have absolutely nothing – barely surviving on $4 a day while the billionaire and millionaire shareholders feast off the bean pickers’ blood, sweat and tears. The American Way. We criticize communists, socialists, Venezuela, Russia, Cuba and others. We are no better than anyone else. Those who support the current system as is, should be ashamed. Do they not have a conscience or know right from wrong? Everyone else must boycott companies who trounce on their employees. In order to get to the top of the mountain, they stepped on many along the way and those at the top will not change until they realize that it is more costly not to change.
|
|
The construction of this website was completed in May 2014
|
|
There are profiles for 24 wonderful, highly regarded, honest and efficient charities (philanthropy). These organizations are doing God’s work and we must support them. THERE IS NO EXCUSE not to support these charities. There are also profiles for 24 philosophers (philosophy). You will find links to all profiles on the Profiles page and on the left and right columns of this Home page. All profiles run three to four pages in length.
|
|
Philanthropy means love of humanity in the sense of caring, nourishing, developing and enhancing what it is to be human on both the benefactors and beneficiaries. The most conventional modern definition is private initiatives, for public good, focusing on quality of life. Instances of philanthropy commonly overlap with instances of charity, though not all charity is philanthropy, or vice versa. The difference commonly cited is that charity relieves the pains of social problems, whereas philanthropy attempts to solve those problems at their root causes.
|
|
Philosophy is the study of general and fundamental problems, such as those connected with reality, existence, knowledge, values, reason, mind, and language. Philosophy is distinguished by its critical and systematic approach and its reliance on rational argument. The word "philosophy" comes from the Ancient Greek word philosophia, which literally means love of wisdom. The introduction of the terms "philosopher" and "philosophy" has been ascribed to the Greek thinker Pythagoras.
|
|
As Winston Churchill said-- As Winston Churchill said-- If you have an important point to make, don't try to be subtle or clever. Use a pile-driver and hit the point once. Then come back and hit it again. Then hit it a third time, with a tremendous whack. So here is my whack - a beautiful website that took six months to construct. I will spend the rest of my life driving traffic to this site in an effort to seek justice; to educate; raise awareness; encourage more activism, philanthropy and charity. Please spend some time here and look at the site on a nice size computer monitor with an updated browser -- not a small cellphone screen. Please support what we are doing and support a few of the 24 wonderful organizations who we are promoting. |
|
In 1932 William Allen White was quoted-- If our colleges and universities do not breed men who riot, who rebel, who attack life with all the youthful vision and vigor, then there is something wrong with our colleges. The more riots that come out of our college campuses, the better the world for tomorrow. He spoke as he believed. He did not conceal his concern in comforting words. He did not delude his readers or himself with false hopes and with illusions. This spirit of honest confrontation is what America -- and countries outside America -- needs today. I want the world to change and because speaking nicely has gotten the poor (and those speaking on their behalf) nowhere, I will use a more aggressive approach that may at times be humiliating to those I blame for the current condition.
|
|
My words will be straight and to the point
|
|
I will not try to please everyone. I am nauseated and disgusted by what I see in this country. We should be ashamed of ourselves as a society -- allowing 3,000,000 children around the world to starve to death every year. We allow the tobacco industry to slaughter 5,000,000 people every year including 500,000 innocent second-hand smoking victims. In China alone, 180,000,000 children are exposed to the second-hand smoke this disgusting and criminal tobacco industry produces. We allow the COO at Yahoo, who was recently fired, to walk away after fifteen months of underperformance, with a pay package that is 2,000 times what an American soldier in Afghanistan is paid and 4,000 times what minimum wage workers in the services sector earn. We treat service providers and others like servants. We undervalue, under appreciate and underpay them.
|
|
Wealth Redistribution
|
|
Increasing the minimum wage alone will not work -- the only solution is wealth redistribution and that does not have to come exclusively via tax increases. It can come via closing tax loopholes; capping executive compensation at a multiple of what the lowest paid worker is earning or what the median wage is at the respective company; it can come via the wealthy subsidizing healthcare coverage for those who have none, and it can come via more charitable donations. We are only giving 1.5% of GDP to charity. That is an embarrassingly low figure – disgraceful, indefensible and inexcusable. We need to double or triple this. If we do, we can eliminate poverty in the US and have a lot of money left over to start tackling the problem overseas.
|
|
The United States is not about the upper class bubbles in places such as Greenwich, Connecticut; Beverly Hills, California; and The Hamptons in New York -- even though many of these people think the world revolves around them and their $40,000,000 mansions, $10,000,000 yachts, $200,000 cars, $50,000 necklaces and $10,000 handbags. It is about places like Camden, New Jersey -- the murder rate capital of the US. The city was profiled in a heartbreaking article in the May 2014 issue of GQ magazine. 3,000 abandoned buildings --zero movie theaters. 175 drug dealer locations -- two supermarkets. People living with rats and roaches with 14-year old children carrying guns for protection.
|
|
I may introduce a comprehensive bill/proposal in 2015-2016 via this website to address all that I am fighting for and against -- that hopefully will be passed in Washington before all is said and done. Please support what I am doing in any way you can and forward the link to this website to friends and relatives.
|
|
Excerpts below are from my 44-page report (red link at top of page)
|
|
Malnutrition now impacts 15% of the world population -- more than one billion people. Every year, as many as three million children die from hunger-related causes. Almost one billion people do not have access to clean drinking water. More than two billion people live without basic sanitation infrastructure. More than one million children die every year from illness caused by dirty water and unhygienic living conditions. Half of the world population - 3.5 billion -- still live on less than $4 a day.
|
|
48,000,000 people in this country are on food stamps, but still many in the upper class (who sit on tens of trillions of dollars) look to limit social services while cheating on their taxes and complaining about the debt that is where it is because of that cheating. Food stamps for those struggling to survive are not handouts -- subsidies, tax loopholes and tax breaks to highly profitable companies are handouts.
|
|
Apple (and other extreme capitalists) are apparently in The Race to the Bottom. Where will they go next? Are they looking for a country in Africa where they can find workers to work for $1.00 an hour now that suicides in China and bad publicity are pressuring wages there higher -- from less than $2.00 an hour towards (and past) $3.00 an hour?
|
|
Whether or not Apple has recently changed the way it does business, does not change the fact that reparations are due for the many years of abuse. Apple has zero tolerance for any quality issues related to their products – abusing workers is acceptable though – for that they have plenty of tolerance. It is crystal clear that a lower level of urgency apparently applies in responding to labor rights abuses. China Labor Watch investigations revealed at least 86 labor rights violations, including 36 legal and 50 ethical violations at Apple supplier facilities.
|
|
Apple assembly line workers were paid $2 an hour and housed in 200 square-foot dormitories that held 12 residents. Dozens of suicides were registered. Factories did not provide enough safety equipment and training, and at no time during the hiring or thereafter were workers informed about the likely harm to their health. Facilities contained harmful substances such as toluene, formaldehyde, lead smoke, ethanolamine, butanone, isopropyl alcohol, carbon dioxide, and laser radiation.
|
|
Since its founding, Amazon has attracted criticism and has been involved in controversy from multiple sources over its actions. These include luring customers from the site's brick and mortar competitors; poor warehouse conditions for workers; anti-unionization efforts; taking public subsidies; dodging taxes; anti-competitive actions; price discrimination; and decisions over whether to censor or publish content (to name a few).
|
|
Jeff Bezos knows he will not be able to generate sufficient earnings per share in order to justify the overvalued ($400) Amazon share price (Q1, 2014) unless he is rough towards his employees, cuts expenses, dodges taxes and cripples his competition.
|
|
An Amazon (UK) petition alleged that 15,000 workers in the e-commerce company employed for the holiday rush won't earn enough to buy the bare essentials for life. Jeff Bezos' net worth is $27 billion. Their European warehouses employ foreign temp workers who have no voice. There is a great fear of being sent back home without having received money. As long as this works, Amazon is going to continue with this practice.
|
|
I am sure many in the upper class feel that anything near $10 an hour is a fair wage while they are making $100 - $1,000 an hour. There are some who make $10,000 an hour. Yahoo CEO Mayer and her fired Lieutenant are closer to $20,000 an hour and Jeff Bezos is at $200,000 an hour (if we divide his net worth by 20 years at Amazon). In one hour he makes what his employees would have to work ten years for and be abused in the process – warehouse workers were covering 15 miles per shift for $10 an hour – than is nearly twice the distance that a waitress logs.
|
|
I encourage investors and consumers to cut back on their support of Amazon until Jeff Bezos pays back his multi-billion dollar debt to employees from the last 20 years. How do we continue to support a man who made $27 bln and left his employees with nearly nothing? It is time for us to cap executive compensation and require that a percentage of the profit goes to employees before shareholders gain off of their blood, sweat and tears. We need to hold ethical and less profitable names in our retirement plans and work a bit past age 65 to offset the gains from unethical companies we are forfeiting in protest.
|
|
Some of Britain's largest chains have called for a crackdown on Amazon's tax arrangements. It is a form of piracy capitalism. They move into people's countries, take the money out, and then dump it in some port of convenience such as Luxembourg. It is an ugly return to a form of exploitative capitalism that we had a century ago.
|
|
We went to war over 3,000 deaths on 11-Sept-01. Why are we not going to war against the tobacco industry that is responsible for the extermination of 5,000,000 Americans and 50,000,000 worldwide since 11-Sept-01? In China alone, 740 million people, including 180 million children, are impacted by secondhand smoke. Each year, more than one million people die of diseases related to smoking in China and there are another 100,000 deaths related to secondhand smoke.
|
|
The tobacco industry should be blacklisted. It should be an illegal product. Fund managers and individual investors should sell their shares and pull their support away from this industry.
|
|
Smoking kills more people in the US than murder, AIDS, suicide, drugs, car crashes and alcohol combined, and secondhand smoke kills more than 38,000 Americans a year.
|
|
Tobacco companies and the federal government reached an agreement on publishing corrective statements that say the companies lied about the dangers of smoking and requires them to disclose smoking's health effects, including the death of more than 400,000 people per year in the US. The companies must publish full-page ads in the Sunday editions of 35 newspapers and air prime-time television commercials on CBS, ABC or NBC five times per week for a year.
|
|
About 44 million Americans still smoke. 50% will die from smoking related diseases and 66% of those deaths will be before age 65. As always, it is the minorities and less educated who will pay the highest price. Almost 40% of these people smoke versus just 10% for those with a college degree -- and significantly lower than that for those with a graduate degree.
|
|
We must pressure fund managers and investors to blacklist and eliminate tobacco stocks from their portfolios. When we own a share in a company like Philip Morris, we are in effect supporting what they do and are to a certain extent a partner in their crimes.
|
|
Decades from now, people will be in disbelief when they hear about the way we live today -- just as many of us today are in disbelief at how people lived centuries ago. Slavery was accepted in this country just 150 years ago and segregation existed up until 50 years ago. Most people who read this report (slowly) will agree that we really have made little progress.
|
|
For whoever has a problem with my demand for redistribution of wealth, I suggest you switch places for a few years with someone in the services sector who lives in a bad neighborhood and is taking home less than $500 a week. No person working 40 hours a week should be forced to live below or near the poverty line. This may be the land of opportunity, but it is not a land of equal opportunity. It is easy for people earning $200,000 or $2 million or $20 million a year (after taxes) to justify in their own minds that they are worth this kind of money and expect others to live on $20,000. There is NO way to justify this selfishness.
|
|
Apple needs to pay reparations to workers in Asia – when they are done paying off this debt, maybe they can think about building a factory here in the US and creating 25,000 jobs. We should begin to wipe out the US tobacco industry in VA, NC & KY and replace the lost jobs via Apple and Amazon facilities. Apple and Jeff Bezos have cash and cash equivalents near $200 bln – with all due respect to iPhones and overnight book deliveries -- it is high time for them to give something back to the society they have ripped off and abused for so long.
|
|
Maybe we are the richest country in the world, but they say money is the root of all evil and we got to this # 1 ranking in part via evil, immoral and unethical behavior. Oftentimes, in order to reach the top, you have to step on people along the way. That is what Amazon, Apple, Philip Morris and others in this capitalist society have done - even though the public relations machines behind these giants have fooled you into thinking otherwise.
|
|
I was in landlocked Nepal a couple of years ago. The population there is 27 million. GDP per capita is less than $800. Apple, in cash, is sitting on more than seven times what the entire Nepal economy produces ($20 bln). Most people in Nepal will never leave their country and will never see a beach. I visited a shallow lake near Kathmandu. The kids were playing in there. That is the same water they urinate in, bathe in and wash their clothes and dishes in. For many there, a good day is finding food in the garbage. It is hard to believe that we have people in this country who earn hundreds of thousands of dollars a year (or more), cheat on their taxes and give little or nothing to those who are struggling to survive.
|
|
I do not believe in the trickle-down theory. Nothing ever trickles down to the poor except minimum wage jobs and bread crumbs. Not everyone has the opportunities, circumstances and abilities to succeed as those who have succeeded.
|
|
This massive concentration of economic resources in the hands of fewer people presents a significant threat to political and economic systems. Instead of moving forward together, people are increasingly separated by economic and political power, inevitably heightening social tensions and increasing the risk of a breakdown in society.
|
|
Yahoo COO (de Castro) was fired recently (2013) after 15 months. It was estimated that his compensation package will reach $109 million. That is $350,000 per workday – that is what people in the services sector have to work 15 years for -- and he was fired for under-performance. How anyone can argue against redistribution of wealth after reading this 44-page report is beyond me.
|
|
No one in this country should be earning less than $15 per hour. The problem with a $15 minimum wage is that some businesses could not afford that. A raise to $15 would be the difference between registering a profit versus a loss for some. Employers would then be forced to fire workers and push the extra workload on those who remain. That is why there needs to be a redistribution of wealth in this country where there would be elimination of loopholes and tax havens coupled with new and higher taxes on the upper class -- with that revenue being directly transferred to anyone working for less than $15 an hour.
|
|
How do we accept that 1% of the world population controls $110 trillion dollars while the median wage worldwide is less than $4 a day? That is 3.5 billion people in this world living off less than $1,500 per year – that is what many in this country spend at Starbucks annually. Do people not realize that sending $4 a day to someone in the bottom 50% doubles or triples their standard of living? Why are we as selfish as a society and only giving 1.5% of GDP to the poor with many giving nothing at all?
|
|
We should not give up the fight until everyone lives on a decent income – at least a few times what is now considered to be extreme poverty. Half of the world population lives on less than $4 a day (with half of those below $2 a day). If my push for wealth redistribution is successful, everyone could be lifted above $5 a day by 2020.
|
|
The wealthy, democrats included, and especially the conservatives just don't get it – eventually they will. People rarely get to the top of the mountain without stepping on people along the way and disregarding ethics, values and morals. As I have been claiming all along -- and Robert Kennedy did in the speech below from 46 years ago -- that is how we got to the top of the (GDP per capita) mountain and that is how the wealthiest individuals and largest companies -- Apple, CVS, Amazon, Starbucks, Walmart and Philip Morris to name a few -- got to where they are.
|
|
We have millionaires and billionaires in this country who say they are anti-abortion and pro-life but they sit silent as 3,000,000 children starve to death every year. Is this not hypocritical? A child who dies from hunger is a murdered child! If they don't want their tax dollars going to fund abortion, then they should take their money and save the lives of those who are starving to death. Just another excuse why not to pay their fair share.
|
|
I would like to see at least 2,500,000 on the (unique) visitor counter below within two years - before the 2016 Presidential election. It could be the difference between winning and losing for the candidate who is on our side. I can't do this on my own. Your assistance and support is appreciated.
|
|
I want to thank my friends, family, clients, donors, sponsors and www.bimsym.com for helping me construct this beautiful website. |
|
Thank you, |
Ronnie Moas
May 19, 2014
|
|
|

|
|
Arthur Schopenhauer (1788-1860)
|

|
|
Confucius (551-479 BC)
|

|
|
Jacques Derrida (1930-2004)
|

|
|
Karl Marx (1818-1883)
|

|
|
Aristotle (384-322 BC)
|

|
|
George Berkeley (1685-1753)
|

|
|
Plato (428-348 BC)
|

|
|
Rene Descartes (1596-1650)
|

|
|
John Stuart Mill (1806-1873)
|

|
|
Socrates (470-399 BC)
|

|
|
Jean Paul Sartre (1905-1980)
|

|
|
John Locke (1632-1704)
|

|
|
Jean Jacques Rousseau (1712-1778)
|

|
|
Ludwig Wittgenstein (1889-1951)
|

|
|
Michel Foucault (1926-1984)
|

|
|
Martin Heidegger (1889-1976)
|

|
|
Baruch Spinoza (1632-1677)
|

|
|
Immanuel Kant (1724-1804)
|

|
|
David Hume (1711-1776)
|

|
|
Soren Kierkegaard (1813-1855)
|

|
|
Friedrich Nietzsche (1844-1900)
|

|
|
Gottfried Leibniz (1646-1716)
|

|
|
Niccolo Machiavelli (1469-1527)
|

|
|
Bertrand Russell (1872-1970)
|
|
|
Starbucks founder Howard Schultz sits on $2 bln while the coffee-bean pickers barely survive on $4 a day. As much as Schultz has, it pales in comparison to the > $50 billion his shareholders have. As of May 19, 2014 Starbucks was valued at $53.4 billion and the bean pickers have nothing. It is unconscionable, immoral, indefensible and unforgiving that we allow this injustice, inequity and unfairness to continue. Had Starbucks executives treated their American employees as their bean pickers in Central America were treated for decades, they would be thrown in jail. They can't break the law in this country, so they go where they can get away with this disgusting behavior. I am sick and tired of millionaire and billionaire shareholder activists demanding dividend payments. When on Earth will consumers demand that Starbucks pay the bean pickers a dividend? They are, in my opinion due billions of dollars in bonuses and reparations.
|
|
It costs a large amount of money to build this website; maintain it; drive traffic to it; and get this message to the masses. Please go to our Donate page and support what we are doing -- and then support directly any of the exceptional, honest, efficient and first-class organizations we are promoting here at Philanthropy & Philosophy. When you click on any the respective reports, you will have their contact information at the bottom. Please donate to the charities of your choice directly after allocating something to us here -- and share the link to our website with your friends and relatives.
|
|